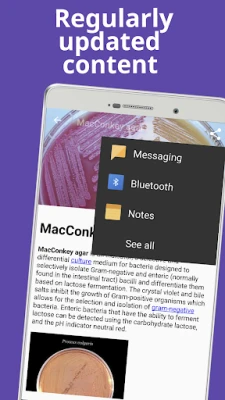

नवीनतम संस्करण
संस्करण
3.9.0
3.9.0
अपडेट
फ़रवरी 16, 2026
फ़रवरी 16, 2026
डेवलपर
99 Dictionaries: The world of terms
99 Dictionaries: The world of terms
श्रेणियाँ
शिक्षा
शिक्षा
प्लेटफ़ॉर्म
एंड्रॉइड
एंड्रॉइड
डाउनलोड
0
0
लाइसेंस
Free
Free
पैकेज का नाम
com.dictionary.cell.biology.cellbiology
com.dictionary.cell.biology.cellbiology
रिपोर्ट
समस्या की रिपोर्ट करें
समस्या की रिपोर्ट करें
Cell biology के बारे में और जानें
Cell biology एक विस्तृत वैज्ञानिक विश्वकोश है। यह ऐप अर्धसूत्रीविभाजन, समसूत्रीविभाजन, साइटोकिन्स, कोशिकीय प्रक्रियाओं, संकेत, गति और वृद्धि कारकों जैसे महत्वपूर्ण विषयों को गहराई से समझाता है। कोशिका जीव विज्ञान की व्यापक जानकारी के लिए यह एक उपयोगी संदर्भ है।
क्या आप जीवन की सबसे छोटी इकाई, कोशिका के रहस्यों को जानने के लिए उत्सुक हैं? "science dictionary cellular biology book free offline" कोशिका विज्ञान की जटिल दुनिया को सरल और सुलभ बनाने वाला एक बेजोड़ डिजिटल संसाधन है। चाहे आप छात्र हों, शिक्षक हों, या केवल विज्ञान के प्रति उत्साही, यह ऐप आपको कोशिकाओं की संरचना, उनके कार्य, रासायनिक घटकों और जीवन प्रक्रियाओं की गहरी समझ प्रदान करता है, जिसमें आनुवंशिकी, जैव रसायन और आणविक जीव विज्ञान जैसे संबद्ध क्षेत्र भी शामिल हैं।
कोशिका के हर कोने को समझें – ऑर्गेनेल से लेकर कोशिका विभाजन तक। यह ऐप माइटोकॉन्ड्रिया की दोहरी झिल्ली संरचना, माइटोसिस द्वारा आनुवंशिक सामग्री के समान वितरण, और अर्धसूत्रीविभाजन (मेयोसिस) द्वारा युग्मक कोशिकाओं के निर्माण जैसे महत्वपूर्ण विषयों पर विस्तृत जानकारी प्रदान करता है। कोशिका के कंकाल यानी साइटोस्केलेटन की भूमिका, जो इसे आकार देता है और ऑर्गेनेल की गति को व्यवस्थित करता है, स्पष्ट रूप से समझाई गई है। इसके अलावा, प्रोटीन के मूल घटक अमीनो एसिड और एंजाइमों के उत्प्रेरक क्रिया तंत्र को भी सहजता से प्रस्तुत किया गया है।
"science dictionary cellular biology book free offline" सिर्फ एक पुस्तक नहीं, बल्कि एक व्यापक ज्ञान का भंडार है जिसमें 7500 से अधिक परिभाषाएं और शब्द शामिल हैं। इसकी उन्नत खोज सुविधा, ऑटो-कंप्लीट के साथ, आपको टाइप करते ही शब्दों का अनुमान लगाकर जानकारी तक तेज़ी से पहुंचने में मदद करती है। वॉयस सर्च की सुविधा से आप बोलकर भी अपनी आवश्यक जानकारी प्राप्त कर सकते हैं। सबसे महत्वपूर्ण बात, यह ऐप पूरी तरह से ऑफ़लाइन काम करता है – डेटाबेस ऐप के साथ ही पैक किया गया है, जिसका अर्थ है कि आपको खोज करते समय किसी इंटरनेट कनेक्शन या डेटा शुल्क की चिंता नहीं करनी होगी। यह ऐप त्वरित संदर्भ और जीव विज्ञान सीखने के लिए एक आदर्श साथी है।
कोशिका के हर कोने को समझें – ऑर्गेनेल से लेकर कोशिका विभाजन तक। यह ऐप माइटोकॉन्ड्रिया की दोहरी झिल्ली संरचना, माइटोसिस द्वारा आनुवंशिक सामग्री के समान वितरण, और अर्धसूत्रीविभाजन (मेयोसिस) द्वारा युग्मक कोशिकाओं के निर्माण जैसे महत्वपूर्ण विषयों पर विस्तृत जानकारी प्रदान करता है। कोशिका के कंकाल यानी साइटोस्केलेटन की भूमिका, जो इसे आकार देता है और ऑर्गेनेल की गति को व्यवस्थित करता है, स्पष्ट रूप से समझाई गई है। इसके अलावा, प्रोटीन के मूल घटक अमीनो एसिड और एंजाइमों के उत्प्रेरक क्रिया तंत्र को भी सहजता से प्रस्तुत किया गया है।
"science dictionary cellular biology book free offline" सिर्फ एक पुस्तक नहीं, बल्कि एक व्यापक ज्ञान का भंडार है जिसमें 7500 से अधिक परिभाषाएं और शब्द शामिल हैं। इसकी उन्नत खोज सुविधा, ऑटो-कंप्लीट के साथ, आपको टाइप करते ही शब्दों का अनुमान लगाकर जानकारी तक तेज़ी से पहुंचने में मदद करती है। वॉयस सर्च की सुविधा से आप बोलकर भी अपनी आवश्यक जानकारी प्राप्त कर सकते हैं। सबसे महत्वपूर्ण बात, यह ऐप पूरी तरह से ऑफ़लाइन काम करता है – डेटाबेस ऐप के साथ ही पैक किया गया है, जिसका अर्थ है कि आपको खोज करते समय किसी इंटरनेट कनेक्शन या डेटा शुल्क की चिंता नहीं करनी होगी। यह ऐप त्वरित संदर्भ और जीव विज्ञान सीखने के लिए एक आदर्श साथी है।
ऐप को रेट करें
टिप्पणी और समीक्षा जोड़ें
उपयोगकर्ता समीक्षाएं
0 समीक्षाओं पर आधारित
अभी तक कोई समीक्षा नहीं जोड़ी गई है।
यदि टिप्पणियाँ स्पैम, अपमानजनक, विषय से हटकर, अभद्र भाषा का उपयोग करती हैं, व्यक्तिगत हमला करती हैं, या किसी भी प्रकार की घृणा को बढ़ावा देती हैं, तो उन्हें पोस्ट करने के लिए स्वीकृत नहीं किया जाएगा।
अधिक »










लोकप्रिय ऐप्स

Librera PRO: किताब पढ़ने वालाLibrera

Fuelio: Fuel log & fuel pricesSygic.

Bengali Matrimony Marriage AppMatrimony.com Ltd.

The Hindu ePaper: eNewspaperTHG Publishing Private Limited

Immune WarCrazyTaowa

VCB DigibankVietcombank

डिजिखटा - आय खर्च & बजट बुकDigiKhata Business Apps

इम्यूनोलॉजी पाठ्यक्रमAPLUS

Cameo - Personal celeb videosCameo - Personalized Shoutouts

AUTOsist Fleet Maintenance AppAUTOsist